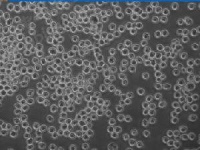

原代培养
原代培养是指直接从机体取下细胞、组织和器官后立即进行培养。因此,较为严格地说是指成功传代之前的培养,此时的细胞保持原有细胞的基本性质,如果是正常细胞,仍然保留二倍体数。但实际上,通常把第一代至第十代以内的培养细胞统称为原代细胞培养。最常用的原代培养有组织块培养和分散细胞培养。
基本介绍(primary culture)[编辑 | 编辑源代码]
原代培养也称初代培养,严格的说即从体内取出组织接种培养到第一次传代阶段,但实际上,通常把第一代
至第十代以内的培养细胞统称为原代细胞培养。一般持续1一4周。此期细胞呈活跃的移动,可见细胞分裂,但不旺盛。初代培养细胞与体内原组织在形态结构和功能活动上相似性大。细胞群是异质的(Heterogeneous),也即各细胞的遗传性状互不相同,细胞相互依存性强。如把这种细胞群稀释分散成单细胞,在软琼脂培养基中进行培养时,细胞克隆形成率(Cloning Efficiency)很低,即细胞独立生存性差。克隆形成率即细胞群被稀释分散成单个细胞进行培养时,形成细胞小群(克隆)的百分数。初代培养细胞多呈二倍体核型;由于原代培养细胞和体内细胞性状相似性大,是检测药物很好的实验对象。
也称初代培养,即从体内取出组织接种培养到第一次传代阶段,一般持续1一4周。此期细胞呈活跃的移动,可见细胞分裂,但不旺盛。初代培养细胞与体内原组织在形态结构和功能活动上相似性大。细胞群是异质的(Heterogeneous),也即各细胞的遗传性状互不相同,细胞相互依存性强。如把这种细胞群稀释分散成单细胞,在软琼脂培养基中进行培养时,细胞克隆形成率(Cloning Efficiency)很低,即细胞独立生存性差。克隆形成率即细胞群被稀释分散成单个细胞进行培养时,形成细胞小群(克隆)的百分数。初代培养细胞多呈二倍体核型;由于原代培养细胞和体内细胞性状相似性大,是检测药物很好的实验对象。
分类[编辑 | 编辑源代码]
最常用的原代培养有组织块培养和分散细胞培养。
组织块培养是将剪碎的组织块直接移植在培养瓶壁上,加入培养基后进行培养。
分散细胞培养则是将组织块用机械法或化学法使细胞分散。如欲从胎儿或新生儿的组织分离到活性最好的游离细胞,经典的方法是用蛋白水解酶(如胰蛋白酶和胶原酶)消化细胞间的结合物,或用金属离子螯合剂(如EDTA)除去细胞互相粘着所依赖的Ca2+,再经机械轻度振荡,使之成为单细胞。
实验[编辑 | 编辑源代码]
实验目的[编辑 | 编辑源代码]
能独立地进行细胞的原代培养,争取原代培养一次成功。
实验原理[编辑 | 编辑源代码]
细胞培养是生物学和医学研究最常用的手段之一,可分为原代培养和传代培养两种。原代培养是直接从生物体获取细胞进行培养。由于细胞刚刚从活体组织分离出来,故更接近于生物体内的生活状态。这一方法可为研究生物体细胞的生长、代谢、繁殖提供有力的手段,同时也为以后传代培养创造条件。利用此方法还可直接服务于临床实践。例如,用从手术中切除的肿瘤细胞进行原代培养,然后用该培养细胞进行抗癌药物的筛选,根据肿瘤细胞对加入的化疗药物的敏感性来帮助选择最有效的化疗方案,有可能起到增强疗效、降低副作用的作用。原代培养可分为消化法和组织块培养法,这里统一作介绍。
实验材料和用品[编辑 | 编辑源代码]
材料:培养瓶,青霉素瓶,小玻璃漏斗,三角烧瓶,平皿,吸管,试管,移液管,无菌纱布,无菌眼科剪,废液缸,血球计数板,蜡盘,手术器械,大头针,离心管。孕鼠或新生1。4d乳鼠,75%酒精棉球,2%碘酒。
药品:培养基(RPMI1640或DMEM),小牛血清,0.125%胰蛋白酶,Hanks液,75%酒精,双抗(青霉素和链霉素)。
仪器(请参看仪器图库):CO2培养箱.;倒置显微镜,超净台,磁力搅拌器,离心机。
实验步骤[编辑 | 编辑源代码]
1.取材(以胚胎小鼠为例):将孕鼠拉颈椎处死,投入75%酒精浸泡数秒消毒,提出孕鼠控掉酒精,放置于蜡盘中用大头针固定。用手术器械逐层分离皮肤和肌肉组织,打开腹腔。注意不同的解剖层次使用不同的消毒器械。最后取出双角子宫置于无菌平皿内。
2.用Hanks液洗涤3次,剪开子宫取出胚胎。除去子宫、血液和筋膜等组织。
3.用弯头剪把胚胎尽量剪碎,每个组织块小于1mm3。在操作时应尽量将平皿盖半盖住平皿以防空气中尘埃落下污染组织。再用Hanks液洗涤2-3次,自然沉淀。用吸管吸去上清液。以下可按两种方法进行,即消化法和组织块培养法。
4.若使用消化法,则将组织块放人三角烧瓶内加入10-30mL0.125%胰蛋白酶,37℃磁力搅拌消化20多min。然后加人少量血清终止消化。用几层无菌纱布过滤。取过滤液,800r/min离心5-10min收集细胞。弃上清,加入带有双抗的培养基,放入培养瓶中培养。
5.若进行组织块培养,则不做步骤4,加入几滴血清于组织块中,再用弯头吸管将组织块悬液吸起。在一小培养瓶中逐个铺展开,注意将瓶底涂抹均匀。将瓶子翻转倒置后在37℃培养箱内放置2-3h。待组织块微干与瓶壁粘牢后再轻轻将瓶子翻转过来,从边角加入4-5mL培养基,使细胞接触到培养基,放培养箱内继续进行培养。
操作要领[编辑 | 编辑源代码]
混匀操作要领[编辑 | 编辑源代码]
(1)火焰消毒吸管,用Hanks液冷却和湿润管内壁(这是因为刚分离的组织细胞易粘在管壁上)
(2)吸管头插入管底
(3)用吸管反复轻轻吹打组织块
器械的使用[编辑 | 编辑源代码]
(1)用工作台消毒镊子取浸泡在酒精中消毒的器械。
(2)器械置无菌干纱布内嚓一下。迅速通过火焰,冷却后使用。
(3)用过的器械置另一加盖的器皿中再消毒。
(4)器械按浸泡消毒的顺序使用。
(5)各套再消毒器械不可混用。
除去组织块多余水分[编辑 | 编辑源代码]
用吸管将组织块推向青霉素瓶一角,然后将有组织块的瓶面翻向上方,吸去流向对侧的多余水分。
注意:多余水分若不除去,会使组织块剪切不细,消化后的细胞悬液清亮(细胞数少),并可见消化液中消化液中有线状或絮状物漂浮。
细胞计数[编辑 | 编辑源代码]
(1)用吸管混匀待计数的细胞悬液。
(2)将一小滴细胞悬液从盖玻片与载玻片交界部位滴入细胞计数池中。
(3)沉降1分钟,低倍镜下计数血球计数板四大中格的结构完整的细胞,小细胞团计数为1。
(4)计数时,如果细胞压在格上,则数上不数下,数左不数右。然后按下式计算出每毫升悬液中的细胞数。
(四大中格细胞数/4)*10000=细胞数/毫升
注意事项[编辑 | 编辑源代码]
一、注意污染
1、严格进行动物皮肤消毒,使用三套器械取材。新生动物皮肤先用2%碘酒液消毒,成年鼠先用3%~5%碘酒液消毒后用75%酒精消毒。
2、严格进行无菌操作,防止细菌、霉菌、支原体污染,避免化学物质污染。
3、吸取液体前,瓶口和吸管硬行火焰消毒;吸取液体时,避免俩这碰撞。
4、离心管入台前,管口、管壁应消毒。
5、实验者离开超净台时,要随时用肘部关闭工作窗。
6、使用过的器械用酒精棉球嚓去血污后,移入另一个器皿中继续消毒,在浸泡器械时剪刀口要叉开放,镊子弯头要向下放,并加盖消毒。二、器材使用时既要注意用火焰消毒,又要防止烫伤、烫死细胞。经火焰消毒后的吸管一定要用Hanks液冷却。
三、超净台内温度、湿度较大,在夏天工作时台内散热更慢,因此进行细胞悬液混匀、接种时,离火焰要稍微远些。